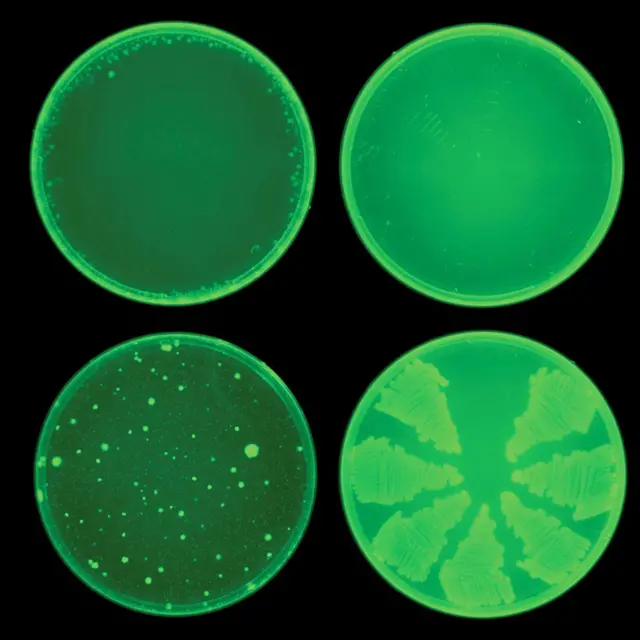
Ilustração de compostos antibióticos e bactérias ao microscópio

Crédito, Getty Images
- Author, Laurie Clarke
- Role, BBC Future
Há 12 minutos
Tempo de leitura: 11 min
Nossas armas mais poderosas nesta luta são os antibióticos. Mas a resistência vem se espalhando, fazendo com que eles se tornem cada vez menos eficazes.
Atualmente, cerca de 1,1 milhão de pessoas morrem todos os anos de infecções que, até recentemente, eram facilmente tratadas. E este número deve aumentar para mais de oito milhões até 2050, a menos que sejam tomadas medidas urgentes.
Mas o desenvolvimento de novos antibióticos é um processo lento, caro e frustrante.
Entre 2017 e 2022, apenas 12 novos antibióticos foram aprovados para uso. A maioria deles é similar a tipos já existentes, aos quais as bactérias já estão desenvolvendo resistência.
A falta de financiamento e de interesse das companhias farmacêuticas fez com que este campo fosse cronicamente negligenciado.
Mas, agora, os pesquisadores estão tentando solucionar este problema. E alguns deles apostam na inteligência artificial (IA) para ajudá-los.
"Em questão de dias ou horas, podemos examinar imensas bibliotecas" de compostos químicos para identificar quais exibem atividade antibacteriana", afirma o professor de ciências e engenharia médica James Collins, do Instituto de Tecnologia de Massachusetts (MIT, na sigla em inglês) na cidade de Cambridge, nos Estados Unidos.
Com a ajuda da IA, Collins e sua equipe já descobriram dois novos compostos que poderão se tornar armas vitais contra a gonorreia e a Staphylococcus aureus resistente à meticilina (SARM), duas infecções altamente resistentes aos medicamentos atuais.
Este é apenas um exemplo de como a IA vem abrindo uma nova era de descoberta de medicamentos, que promete trazer progressos em relação a alguns dos problemas médicos de mais difícil tratamento dos tempos atuais.
Os cientistas, agora, empregam a IA para examinar condições sem cura conhecida, como Parkinson, e milhares de doenças raras, na esperança de novas descobertas.
Collins e sua equipe treinaram um modelo de IA generativa para reconhecer as estruturas químicas de antibióticos conhecidos. Isso permitiu que o algoritmo aprendesse o que causa a morte das bactérias.
Em seguida, os pesquisadores usaram a IA para examinar mais de 45 milhões de estruturas químicas diferentes, determinando sua capacidade de combater as bactérias Neisseria gonorrhoeae, a causadora da gonorreia, e Staphylococcus aureus, uma fonte significativa de infecções na forma de SARM.
Crédito, Collins Lab/MIT
Estas duas bactérias são altamente resistentes às drogas. A gonorreia, por exemplo, consegue escapar de quase todos os remédios usados para o seu tratamento.
Com isso, o número de antibióticos disponíveis como último recurso contra cada uma delas é cada vez menor. E o método empregado por Collins usa a IA para criar compostos inteiramente novos para combatê-las.
Em uma das técnicas, ele selecionou uma molécula como ponto de partida e empregou uma combinação de técnicas de IA generativa para desenvolvê-la, "acrescentando ligações, átomos e subestruturas", explica ele.
A cada estágio crítico, o seu modelo de IA treinado avaliava o composto. "Este composto se parece com um antibiótico? Está chegando perto de um possível antibiótico?"
Outra abordagem envolveu a eliminação do composto inicial, permitindo que a IA navegasse livremente desde o princípio.
Desta forma, Collins e seus colegas projetaram 36 milhões de compostos com uso potencial contra as bactérias e selecionaram 24 deles para síntese em laboratório.
Destes, sete apresentaram alguma atividade antimicrobiana e dois foram altamente eficazes para matar linhagens das duas bactérias resistentes a outros tipos de antibióticos.
É importante destacar que os compostos aparentemente atacam as bactérias de formas diferentes dos antibióticos já existentes. Isso aumenta a esperança de que eles venham a formar uma nova classe de medicamentos, capaz de superar as defesas das bactérias resistentes a drogas.
As duas substâncias se encontram atualmente em fase de testes.
Collins e seu laboratório já haviam empregado a IA para descobrir outros compostos antibióticos poderosos e inovadores, que matam uma ampla variedade de bactérias resistentes aos tratamentos. Elas incluem Clostridium difficile, uma infecção intestinal comum, e Mycobacterium tuberculosis, causadora da tuberculose.
Mas, para algumas doenças, os pesquisadores não têm a possibilidade de partir de remédios existentes para ajudá-los a descobrir novos tratamentos. Por isso, eles precisam se basear nos conhecimentos existentes sobre a doença.
E, em alguns casos, estes conhecimentos oferecem poucos pontos de partida.
Progresso sobre Parkinson
A doença de Parkinson foi identificada pela primeira vez em 1871. E, mais de dois séculos depois, ainda não existe tratamento que reduza a sua progressão.
Existem mais de 10 milhões de pacientes com Parkinson em todo o mundo e seu número vem aumentando em países que enfrentam o envelhecimento da população.
No Reino Unido, cerca de uma a cada 37 pessoas será diagnosticada em algum momento da vida. Nos Estados Unidos, até um milhão de pessoas vivem atualmente com a doença.
As contínuas tentativas de tratamento de Parkinson foram marcadas pelo fracasso. Parte do motivo é que ainda não conhecemos as causas da doença.
"Existem debates sem fim sobre a origem da doença", segundo o professor de biofísica Michele Vendruscolo, um dos diretores do Centro de Doenças Causadas pelo Desdobramento Incorreto de Proteínas da Universidade de Cambridge, no Reino Unido.
"Se você for a uma conferência sobre Parkinson, ouvirá dezenas de hipóteses diferentes, todas elas sendo ativamente pesquisadas", explica ele.
Isso dificulta incrivelmente o desenvolvimento de um medicamento para evitar a doença.
Existe uma enorme quantidade de testes clínicos investigando diferentes hipóteses. Mas, até o momento, não houve sucesso, segundo Vendruscolo.
"As pessoas realmente estão confusas sobre qual deve ser o objetivo", afirma ele. "E, mesmo se você souber qual é o alvo, costuma ser muito difícil tentar atingi-lo."
Mas, em 2024, Vendruscolo e seus colegas publicaram um estudo empregando aprendizado de máquina (uma forma de inteligência artificial) para buscar possíveis medicamentos capazes de agir sobre os grupos de proteínas desdobradas incorretamente no cérebro, encontradas em pacientes com Parkinson.
Acredita-se que esses conjuntos de proteínas, conhecidos como corpos de Lewy, participem dos estágios iniciais da neurodegeneração em pacientes com Parkinson, eventualmente gerando sintomas que incluem tremores, lentidão de movimentos e rigidez muscular.
Atualmente, o tratamento mais eficaz contra o Parkinson é o medicamento levodopa, que ajuda a melhorar os sintomas da doença. Mas ele também pode causar efeitos colaterais, como movimentos involuntários.
Vendruscolo trabalha para suspender a progressão da doença. Ele e sua equipe começaram com um conjunto de compostos que já havia sido identificado como potencialmente eficaz para o tratamento dos corpos de Lewy.
O pesquisador alimentou esses compostos em um programa de aprendizado de máquina, que extrapolou suas estruturas químicas para propor novos compostos que também poderão ser eficazes.

Crédito, Getty Images
Para o tratamento de doenças neurodegenerativas, como Parkinson, os medicamentos precisam ser suficientemente pequenos para poderem atravessar a barreira hematoencefálica.
Mas, mesmo se os cientistas restringirem sua caça às moléculas pequenas, "a quantidade de opções ainda será gigantesca", explica Vendruscolo. "O número de possíveis moléculas pequenas é muito maior que o número de átomos do Universo."
O poder da IA pode reduzir esta busca com muita rapidez.
"Podemos analisar estes dados e fazer previsões muito precisas sobre a forma em que as possíveis moléculas se unem ao alvo em escala impensável até alguns anos atrás", segundo Vendruscolo.
Com os métodos mais tradicionais, os cientistas podem selecionar cerca de um milhão de moléculas em seis meses, ao custo de vários milhões de dólares.
"Agora, você pode fazer o mesmo em poucos dias e selecionar bilhões de moléculas, ao custo de alguns milhares de dólares", explica ele.
Os compostos de Vendruscolo, sugeridos por IA, foram testados em laboratório.
"Nós avaliamos quais dos candidatos realmente se ligam [aos corpos de Lewy] e retroalimentamos esta informação para o programa de aprendizado de máquina, para que ele possa aprender com seus próprios erros."
Por fim, eles identificaram cinco novos compostos promissores com mais rapidez e eficácia do que as técnicas convencionais.
Os compostos identificados pela IA também foram muito mais inovadores que os encontrados usando métodos de desenvolvimento mais tradicionais, segundo Vendruscolo.
Agora, os compostos estão passando por novos testes para determinar se, um dia, eles poderão ser oferecidos como produtos terapêuticos para pacientes com Parkinson.
Vendruscolo espera que a IA possa ajudar a suspender a doença de Parkinson antes do seu início. Ele utiliza a tecnologia para encontrar moléculas pequenas que se liguem às proteínas individuais que formam os corpos de Lewy, ainda no seu estado normal.
"Se pudermos estabilizar as proteínas nesta forma, evitaremos o Parkinson, o que é melhor que sua cura", afirma ele.
Novos usos para medicamentos antigos
O tratamento de doenças nem sempre significa criar novos medicamentos.
O professor de medicina David Fajgenbaum, da Universidade da Pensilvânia, nos Estados Unidos, conseguiu salvar sua própria vida com um medicamento existente que os médicos nunca teriam receitado para ele.
Aos 25 anos de idade, Fajgenbaum foi diagnosticado com um raro subtipo de um transtorno conhecido como doença de Castleman, que aciona uma reação imunológica, causando mau funcionamento do fígado, dos rins e da medula óssea.
Ele não reagiu a nenhum dos tratamentos disponíveis e os médicos disseram que não sabiam o que fazer.
Depois de semanas de testes com seu próprio sangue, pesquisando a literatura médica e tratando a si próprio como uma cobaia humana, ele acabou encontrando uma possível salvação: um modesto medicamento chamado sirolimo, normalmente administrado a pessoas que recebem doação de rins, para evitar a rejeição do novo órgão.
Para surpresa dos seus médicos, ele usou o medicamento e fez retroceder sua doença de Castleman. Agora, ela está em remissão há mais de uma década.

Crédito, M Scott Brauer
A experiência abriu seus olhos para o potencial existente nos milhares de medicamentos que já passaram pelos extensos testes de segurança necessários para sua comercialização. Adaptando essas drogas para outras condições, os pacientes obtêm tratamentos que não seriam disponíveis de outra forma.
Em 2022, Fajgenbaum criou uma organização sem fins lucrativos chamada Every Cure.
Usando aprendizado de máquina, ele compara milhares de medicamentos com milhares de doenças. E os mais promissores são testados em laboratório ou enviados para médicos dispostos a experimentar.
Faigenbaum é o cientista mais conhecido a empregar a IA desta forma. Mas outros já estão fazendo descobertas.
Na Faculdade de Medicina Harvard, nos Estados Unidos, um modelo de IA encontrou cerca de 8 mil substâncias aprovadas que poderão ser redirecionadas para tratar 17 mil doenças diferentes.
A IA está se mostrando particularmente útil para encontrar tratamentos para doenças raras, frequentemente ignoradas pelas indústrias farmacêuticas, devido à falta de incentivo financeiro oferecido pela pequena quantidade de possíveis pacientes.
O redirecionamento de medicamentos existentes também oferece outra oportunidade.
Nos últimos anos, a IA identificou o potencial de redirecionamento de tratamentos existentes para condições raras, como o transtorno cromossômico conhecido como síndrome de Pitt–Hopkins, a doença inflamatória chamada sarcoidose e um raro tipo de câncer renal que aflige crianças jovens, o tumor de Wilms.
Pesquisadores da Universidade McGill em Montreal, no Canadá, utilizaram IA recentemente para redirecionar medicamentos para o tratamento de fibrose pulmonar idiopática (FPI), uma rara e progressiva doença pulmonar, caracterizada por cicatrizes e espessamento do tecido pulmonar.
Sua técnica envolveu a modelagem da progressão da doença com um modelo de IA.
"As doenças complexas, em sua maioria, são dirigidas por uma mudança anormal do estado das células", segundo um dos pesquisadores, o professor assistente Jun Ding, do Departamento de Medicina da Universidade McGill.
"Se pudermos descobrir como a célula passou de saudável para anormal, talvez possamos reverter ou retardar o processo", explica ele.
Em primeiro lugar, os pesquisadores extraíram células pulmonares de participantes saudáveis e pacientes em diferentes estágios de progressão da doença.
Eles empregaram sequenciamento de DNA de alta resolução para gerar grande quantidade de dados. Isso permitiu que eles observassem as mudanças das células ao longo do curso da doença.
Em seguida, eles construíram um modelo de IA generativa que simulasse o processo, mapeando as transições de diversos estados e populações celulares, conforme o avanço da enfermidade.
Durante o processo, a IA também destacaria eventuais biomarcadores que poderiam ser utilizados para diagnosticar a doença e possíveis objetivos terapêuticos.
"Chamamos isso de sistema de doença virtual", segundo Ding.
Tradicionalmente, os medicamentos são testados em animais ou em células humanas isoladas. Eles pretendem usar este mesmo paradigma com a IA, basicamente simulando os efeitos da FPI sobre as células virtuais.
"Os pesquisadores podem então testar os impactos da aplicação de diferentes substâncias para o modelo, sem grandes custos", explica ele.
No estudo de McGill, a IA sugeriu oito possíveis opções de tratamento para FPI. E um candidato promissor é um medicamento normalmente receitado para hipertensão, o que oferece uma opção de baixo custo e comprovadamente segura.
Ding afirma que a IA desenvolvida por ele e seus colegas também poderá ser empregada para outras doenças, como tipos de câncer e condições pulmonares. Sua equipe continua a aprimorar o modelo e diversificá-lo sob diferentes condições.
A FPI teve outra inovação recente graças à IA.
A empresa de descoberta de drogas por IA Insilico Medicine produziu uma possível substância chamada rentosertib. E. Nos testes clínicos de fase 2, a substância se mostrou promissora contra a FPI.
A empresa usou IA para identificar possíveis fraquezas da doença e projetar um medicamento que pudesse combatê-las. A esperança é que, se os testes forem bem sucedidos, o medicamento possa estar disponível até o final da década.
A Insilico Medicine não é a única. Outras empresas também buscam fazer avanços médicos com IA, como a Terray, Isomorphic Labs, Recursion Pharmaceuticals e Schrödinger.
"Acredito que, nos próximos cinco a 10 anos, a maior parte do desenvolvimento de novos medicamentos poderá ser orientada por IA ou até ser totalmente baseada em IA", segundo Ding.
Revolução limitada
Mas, apesar dos avanços oferecidos pela IA, existem limitações.
Muitos dos conjuntos de dados sobre medicamentos são de propriedade das empresas farmacêuticas e de biotecnologia. Isso significa que eles não são disponíveis ao público.
"Você precisa obter os dados sobre as propriedades das substâncias, como absorção, distribuição, excreção e toxicidade", segundo Collins. "Não temos esses conjuntos de dados."
Atualmente, a IA é mais útil no estágio de seleção inicial do processo de desenvolvimento de medicamentos: a identificação de objetivos e a busca de moléculas para atingir aquele propósito.
Estas são apenas duas etapas do longo processo necessário para desenvolver novos medicamentos, o que indica que pode levar algum tempo até que algum desses possíveis tratamentos chegue aos pacientes, se é que isso irá acontecer.
"A IA está revolucionando a descoberta de medicamentos", segundo Vendruscolo. "Mas apenas de formas muito específicas."

 German (DE)
German (DE)  English (US)
English (US)  Spanish (ES)
Spanish (ES)  French (FR)
French (FR)  Hindi (IN)
Hindi (IN)  Italian (IT)
Italian (IT)  Portuguese (BR)
Portuguese (BR)  Russian (RU)
Russian (RU)  2 horas atrás
3
2 horas atrás
3






:strip_icc()/i.s3.glbimg.com/v1/AUTH_59edd422c0c84a879bd37670ae4f538a/internal_photos/bs/2023/l/g/UvNZinRh2puy1SCdeg8w/cb1b14f2-970b-4f5c-a175-75a6c34ef729.jpg)


:strip_icc()/i.s3.glbimg.com/v1/AUTH_08fbf48bc0524877943fe86e43087e7a/internal_photos/bs/2024/o/u/v2hqAIQhAxupABJOskKg/1-captura-de-tela-2024-07-19-185812-39009722.png)







Comentários
Aproveite ao máximo as notícias fazendo login
Entrar Registro